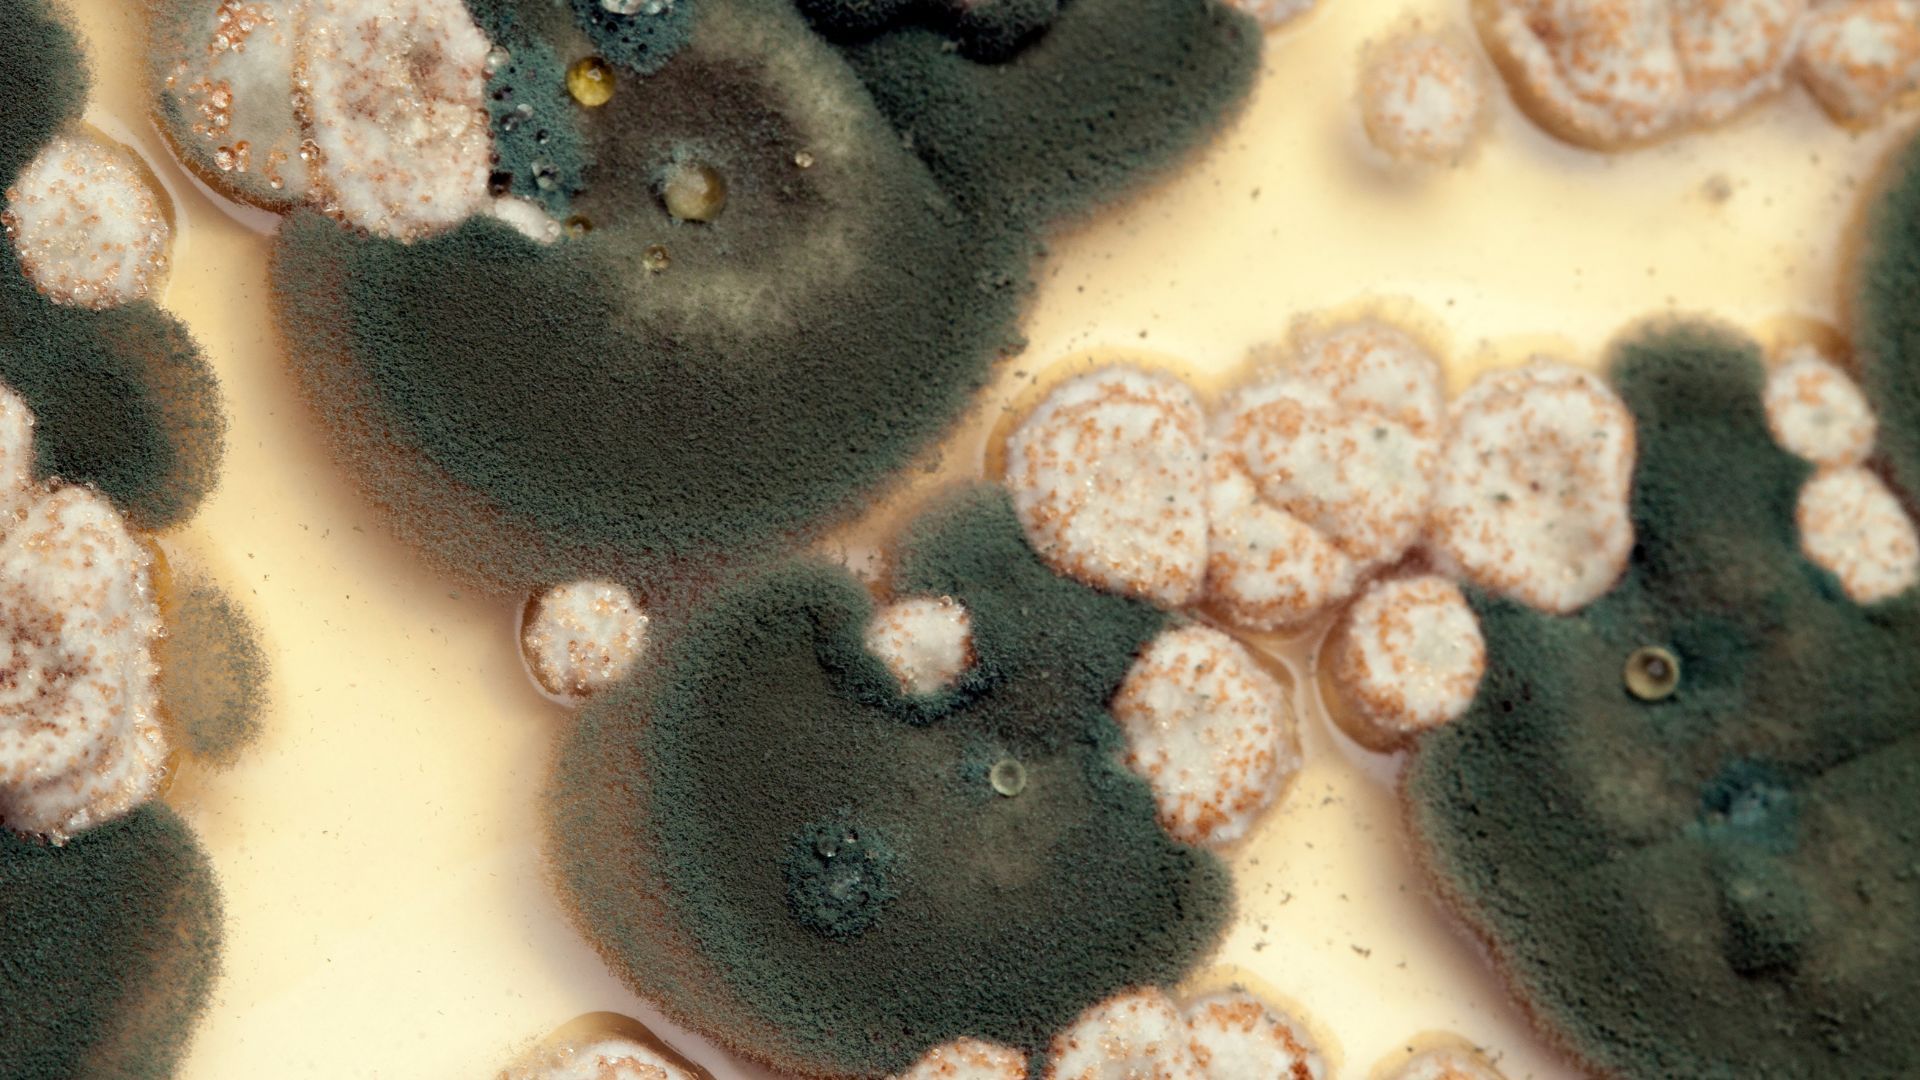
a close up of a mold growing on a piece of food .

About Us
Mold Free Maine


Our Mission
At Mold Free Maine, our mission is to provide unparalleled mold remediation services that safeguard the health and well-being of our clients. We are committed to identifying, removing, and preventing mold with the utmost professionalism and expertise, ensuring a safe, healthy, and mold-free environment for homes and businesses.

Our Vision
Our vision is to be the leading provider of mold remediation services in Maine, recognized for our commitment to quality, sustainability, and customer satisfaction. We strive to educate and empower our community about mold prevention and to set new standards in the industry for safety and effectiveness.

Our Values
Integrity: Upholding honesty and transparency in all our interactions.
Excellence: Delivering superior service and results every time.
Safety: Prioritizing the health and safety of our clients and team.
Innovation: Continuously improving our methods and practices.
Community: Contributing positively to the health and well-being of our community.